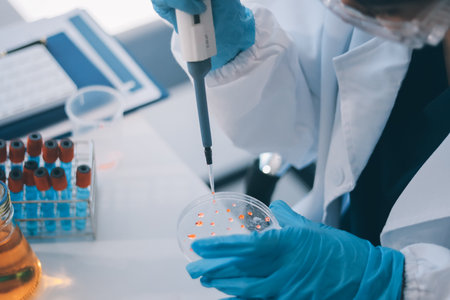
Portrait, science and happy woman on laptop in lab to research chemistry, test or innovation. Microscope, scientist and face of medical doctor in goggles for microbiology, healthcare or pharma studyの写真素材

写真素材 - Portrait, science and happy woman on laptop in lab to research chemistry, test or innovation. Microscope, scientist and face of medical doctor in goggles for microbiology, healthcare or pharma study
作品情報
Portrait, science and happy woman on laptop in lab to research chemistry, test or innovation. Microscope, scientist and face of medical doctor in goggles for microbiology, healthcare or pharma study
- ID:270935255
- 作品種別:写真
- 作者名:armmypicca
キーワード
- adult
- biochemistry
- biology
- biotechnology
- chemical
- chemist
- chemistry
- colleague
- concentration
- curiosity
- development
- discovery
- diversity
- doctor
- drug
- education
- employee
- engineer
- equipment
- examining
- expertise
- explaining
- glove
- hospital
- innovation
- laboratory
- learning
- looking
- medicine
- microbiology
- microscope
- occupation
- pharmacy
- pipette
- portrait
- research
- science
- scientist
- serious
- studying
- teamwork
- technician
- technology
- tube
- uniform
- university
- watching
- wide
- working
類似作品
Computer, scien...
Mad wacky scien...
Showing African...
Optical compari...
Girl looking at...
Smiling mid adu...
Mad foolish sci...
Neon close up p...
Portrait of a b...
Portrait of ind...
Female scientis...
Business woman ...
Two students sm...
Experiment, res...
Young beautiful...
Students in uni...
Portrait, scien...
Portrait of Fem...
A scientific br...
Portrait of you...
Medical Science...
side view of ch...
Biology Student...
female doctor s...
cheerful school...
Female African ...
Women in the Ve...
beautiful laugh...
Happy, night an...
Top view. Conce...
Two Black Women...
Very happy exci...
Image of networ...
Model isolated ...
cheerful teen g...
portrait of a y...
Photo portrait ...
Portraits Of Sm...
Happy young suc...
Laughing young ...
Cute asian scie...
Smile. Portrait...
Portrait of luc...
Lifestyle and p...
Happy positive ...
Smiling woman w...
University stud...
Agricultural En...
Close up of fac...